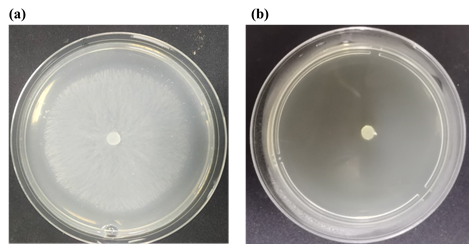

- Introduction
Plant diseases caused by pathogenic fungi can severely reduce the yield and quality of agricultural and forestry crops, exerting huge threat to the food safety worldwide.1 For instance, Sclerotinia sclerotiorum, as a widely distributed pathogenic fungi, can infect various crops and is the main pathogen causing.2 It can invade and damage different parts of rape, often causing watery soft-rot on infected stem and leave tissues.3 Nowadays, chemical pesticides including prochloraz, pyraclostrobin and boscalid, are still the effective method to protect the rape plants from the threat of Sclerotinia soft rot.4 However, the overuse or misuse of these fungicides have led to emerging negative effects, including toxicity to humans and animals and the increasing resistance of target pathogens.5,6 Hence, it is still a hot spot to develop novel fungicides featuring unique mechanisms, improved efficacy and environmental safety for the treatment of rape disease caused by S. sclerotiorum.
Quinoline is a nitrogen heterocyclic compound commonly found in nature, which can be used as a structural component for dyes, resins, and terpene solvents and other chemicals used in the production of large quantities7,8, including insecticides. In medical field, quinoline drugs have multiple biological and pharmacological properties and are commonly used as fungicides, anticancer drugs, and in clinical practice9,10.
Consequently, a series of quinoline derivatives containing camphor scaffold were designed and synthesized. The structures of the title compounds were characterized by their 1H-NMR and 13C-NMR spectra. All the title derivatives were tested for the in vitro antifungal activity toward three pathogenic fungi/oomyectes. In addition, the primarily antifungal mechanism of the most active compoundtoward S. sclerotiorum were also explored.
2. Material and method
2.1 Instruments and Chemicals
1H and 13C NMR spectra were obtained by a Bruker AV-600 spectrometer (Bruker, Germany). Reagents and chemicals of AR grade were obtained from Bide Pharmatech Co., Ltd. and Leyan Chemical (Shanghai, China) and were utilized without further purification.
2.2 Synthetic Procedure of Compounds 3a-3b
Compounds 3a and 3b were both prepared at the lab of Academy of Science and Technology, Chuxiong Normal University.The 2-trifluoromethyl-4-hydroxyquinoline or 2,8-ditrifluoromethyl-4-hydroxy quinoline (1, 1.0 mmol), Et3N (1.1 mmol) and DMAP (0.2 mmol) were dissolved in CH2Cl2 (10 mL) and cooled in ice bath, to which the (1S)-(-)-camphanic acid acyl chloride intermediate (2,1.1 mmol) was added separately. The mixture was reacted at room temperature for 1~3 h. When the reaction was completed, the organic phase was washed with water, dried and evaporated to give the crude product, which was purified by silica gel chromatography (CH2Cl2/MeOH = 20:1, v:v) to afford 3a–3b.
Compound 3a, colorless oil, yield 62%.1H NMR (600 MHz, CDCl3): δ 8.33 (d, J = 8.1 Hz, 1H), 8.23 (d, J = 7.2 Hz, 1H), 7.92 (s, 1H), 7.79 (t, J = 7.9 Hz, 1H), 2.68–2.63 (m, 1H), 2.35–2.30 (m, 1H), 2.11–2.06 (m, 1H), 1.87–1.83 (m, 1H), 1.22 (s, 3H) , 1.21 (s, 3H), 1.19 (s, 3H).13C NMR (150 MHz, CDCl3): δ 177.40, 164.74, 154.60, 149.25, 149.01, 148.77, 145.24, 129.97 (d, J = 5.4 Hz), 129.03 (q, J = 30.7 Hz), 128.00, 125.61, 124.14, 122.81, 122.32, 120.72 (q, J = 273.9 Hz), 109.44, 90.62, 55.10, 55.03, 31.26, 28.83, 16.97, 16.70, 9.70.
Compound 3b, colorless oil, yield 85%.1H NMR (600 MHz, CDCl3): δ 8.27 (d, J = 8.5 Hz, 1H), 8.09 (d, J = 8.2 Hz, 1H), 7.90–7.87 (m, 1H), 7.80 (s, 1H), 7.74 (t, J = 7.5 Hz, 1H), 2.69 – 2.64 (m, 1H), 2.36–2.31 (m, 1H), 2.10–2.05 (m, 1H), 1.87– 1.80 (m, 1H), 1.22 (s, 3H) , 1.21 (s, 3H), 1.20 (s, 3H). 13C NMR (150 MHz, CDCl3): δ 177.47, 164.89, 154.56, 149.01, 148.36 (q, J = 34.9 Hz), 131.58, 130.24, 129.31, 122.24, 121.07 (q, J = 273.8 Hz), 121.20, 108.58, 90.68, 77.21, 77.00, 76.79, 54.99, 54.98, 31.21, 28.85, 16.98, 16.75, 9.70.
2.3 Biological Assay
The detailed experimental procedures for in vitro anti-fungi/anti-oomycetes effects of title compounds11,12, in vivo activity assay, SEM observations13-15were presented in Supporting Information.The in vitro activity assay was conducted at the biology lab of pharmaceutical college, Hebei university.
- Result and dissussion
3.1 Chemistry
The synthetic routes for title derivatives 3a-3b were described in Scheme 1 and Scheme 2. The starting material 2-trifluoromethyl-4-hydroxyquinoline or 2,8-ditrifluoromethyl-4-hydroxyquinoline was reacted intermediate 2 with 60-85% yield. All the structures were characterized by the 1H NMR and 13C NMR spectral analyses.

Scheme 1. The synthetic route of title compounds 3a-3b.

Fig. 1. The 1HNMR spectrum of title compounds 3a.
3.2 In Vitro Antifungal Activity
As depicted in Table 1, compound 3a showed considerable antifungal activities toward S. sclerotiorum and P. capsici at 50 mg/L, with the inhibitiory rate of 100%, which was superior to chlorthalonil (89.7% and 70.5%). Specifically, 3b displayed moderate inhibitionry rate against S. sclerotiorum. This compound presented in vitro good antifungal activity, which still had space for further optimization on structure.
Table 1. In vitro antifungal activities of compounds 3a-3b at 50 mg/L.
| Compd | Inhibition rate (%)a | ||
| B. dothidea | P. capsici | S. sclerotiorum | |
| 3a | 59.0 ± 2.9 | 100 ± 0 | 100 ± 0 |
| 3b | <5 | <5 | 50.2 ± 3.0 |
| (1S)-(-)-camphanic acid | <5 | <5 | <5 |
| chlorthalonil | 88.1 ± 0.5 | 89.7 ± 0.9 | 70.5 ± 0.8 |
a Values are the mean ± standard deviation (SD) of three replicates.
Fig. 2. Mycelium growth and extension of S. sclerotiorum after treatment with different concentrations of compound 3a on agar medium: (a) 0 mg/L; (b) 50 mg/L.
3.3 In vivo activity assay
The results of the in vivo experiment are shown in Table 2. At the concentration of 1000 mg/L, 3a presented good protective effect on pepper plant infected by P. capsici, which was equally with positive control chlorothalonil.

Fig. 3. The in vivo protective effect of compound 3a on pepper plant infected by P. capsici
Table 2. The in vivo protective effect of compound 3a on pepper plant infected by P. capsici
| Compound | Disease index | protective effect (%)a |
| 3a | 0 | 100 |
| chlorothalonil | 0 | 100 |
| Blank control | 80 | – |
a Values are the mean ± standard deviation (SD) of six replicates.
3.4 SEM Analysis
Compound 3a showing the best antifungal actviity toward S. sclerotiorum was chosen for SEM analysis. The culture of S. sclerotiorum were treated with 3a at the concentration of 10 mg/L (Figure. 4). The morphological changes of mycelia were observed through SEM. Aspresented inFigure. 3a, the mycelia in the blank control group presented the entired shape and smooth surface. However, when treated with 0.195 mg/L of 3a (Figure. 4b), the mycelia showed abnormal features. The surface became significantly rough and shrunk to some extent, and some cracks could be observed on the mycelia. These observations presented that 3a could dose-dependently impair the surface morphology of S. sclerotiorum.

Fig. 4. SEM graphs of S. sclerotiorum hyphae treated with (a) 0 mg/L, (b) 10 mg/L. The scale bars for graphs a and b were 20 μm.
- Conclusion
In summary, two novel quinoline derivatives containing camphor scaffold were designed and synthesized. The preliminary antifungal test indicated that the title derivatives showed moderate to good antifungal activity against three plant pathogenic fungi/oomycetes. Among them, compound 3a exhibited the strongest in vitro inhibitory activity against S. sclerotiorum. In the primarily mechanism study, 3a could destroy the morphological structure of S. sclerotiorum hyphae. This work implied that this class of quinoline derivatives containing camphor scaffold could be potential derivatives for the development of novel fungicides.
Rrefernces
- Peng J W, Yin X D, Li H, Ma K Y, Zhang Z J, Zhou R, Wang Y L, Hu G F, Liu Y Q. Design, Synthesis, and Structure–Activity Relationship of Quinazolinone Derivatives as Potential Fungicides, J. Agric. Food Chem. 2021, 69, 4604-4614.
2. Haji J A, Chawishli L H, Samad, M. Design, synthesis and molecular docking study of novel bisoxazolone derivatives as potent antioxidant and antibacterial agents. Bull. Chem. Soc. Ethiop. 2024, 38(5), 1393-1404.
3. Duan Y, Ge C, Liu S C, Zhou M. Effect of phenylpyrrole fungicide fludioxonil on morphological and physiological characteristics of Sclerotinia sclerotiorum, Pestic. Biochem. Physiol. 2013, 106, 61-67.
4. Wang Z, Peng Q, Hou Y, Gao X, Zhong S, Fang, Y. Resistance assessment for SYP-14288 in Phytophthora capsici and changes in mitochondria electric potential-associated respiration and ATP production confers resistance. Pest Manage. Sci. 2020, 76, 2525-2536.
5. Xu H, Fan L. Antifungal agents. Part 4: Synthesis and antifungal activities of novel indole[1,2-c]-1,2,4-benzotriazine derivatives against phytopathogenic fungi in vitro Eur. J. Med. Chem. 2011, 46, 364-369.
6. Wang Q, Mao Y S, Li S X, Li T, Wang J X, Zhou M G, Duan Y B. Molecular Mechanism of Sclerotinia sclerotiorum Resistance to Succinate Dehydrogenase Inhibitor Fungicides. J. Agric Food Chem. 2022, 70, 7039-7048.
7. Mayer A M, Staples R C. Laccase: new functions for an old enzyme, Phytochemistry. 2002, 60, 551-565.
8. Yoshida H. LXIII.—Chemistry of lacquer (Urushi). Part I. Communication from the Chemical Society of Tokio, J. Chem. Soc. Trans. 1883, 43, 472-486.
9. Couto S R, Toca Herrera J L. Industrial and biotechnological applications of laccases: A review, Biotechnol Adv. 2006, 24, 500-513.
10. Smith M, Thurston C F, Wood D A. Multi-copper Oxidases 1997, 201-224.
11. Saparrat M C N, Guillén F, Arambarri A M, Martínez A T, Martínez M J. Induction, Isolation, and Characterization of Two Laccases from the White Rot Basidiomycete Coriolopsis rigida, Appl. Environ. Microbiol. 2002, 68, 1534-1540.
12. Bell A A, Wheeler M H., Biosynthesis and Functions of Fungal Melanins, Annu. Rev. Phytopathol. 1986, 24, 411-451.
13. Wang Z W, Peng Q, Gao X, Zhong S, Fang Y, Yang X L, Ling Y, Liu X L. Novel fungicide 4-chlorocinnamaldehyde thiosemicarbazide (PMDD) inhibits Laccase and Controls the Causal Agent of Take-All Disease in Wheat, Gaeumannomyces graminis var. tritici, J. Agric. Food Chem.2020, 68, 5318-5326.
14. Zhang X M, Xu H, Su F H, Yang X L, Sun T D, Lu X, Shi F S, Duan H X, Liu X L, Ling Y. Design, Synthesis, and Biological Activity of Novel Fungicides Containing a 1,2,3,4-Tetrahydroquinoline Scaffold and Acting as Laccase Inhibitors, J. Agric. Food Chem. 2022, 70,1776-1787.
15. Sun T D, Jin X Y, Zhang X M, Lu X M, Wang C K, Cui J L, Xu H, Yang X L, Liu X L, Zhang L, Ling Y. Design, Synthesis, and Biological Activity of Novel Laccase Inhibitors as Fungicides against Rice Blast, J. Agric. Food Chem. 2022, 70, 14367-14376.